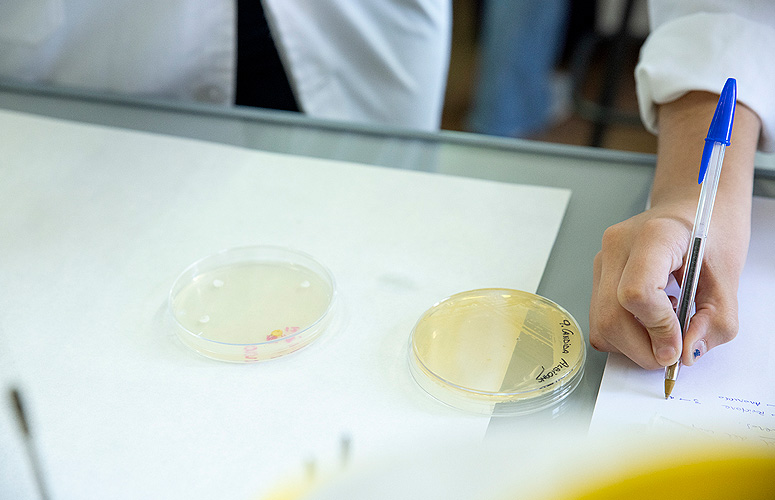

La cantera de la sanidad pública
Hablamos con el alumnado de nuestra universidad que ha obtenido las mejores notas en las pruebas MIR, EIR, PIR, FIR, BIR y RFIR de esta convocatoria
- Reportajes
Fecha de primera publicación: 22/04/2021

El pasado 27 de marzo, miles de estudiantes de universidades de todo el estado se examinaban para lograr una de las plazas con las acceder a la prestigiosa Formación Sanitaria Especializada. Son lo que coloquialmente conocemos como las plazas de MIR (Medicina), EIR (Enfermería), PIR (Psicología), FIR (Farmacia), BIR (Biología), RFIR (Radio Física Hospitalaria) y QIR (Química).
Tras un año de enclaustramiento preparando la crucial prueba, se jugaban a cara o cruz todo ese esfuerzo, para conseguir ser parte de esos equipos que se encargarán de nuestra salud en la Sanidad Pública.
Hablamos con las y los titulados de la UPV/EHU que han obtenido las mejores posiciones con opción a plaza en cada una de esas especialidades. Valga también como reconocimiento a todas esas y esos EHUalumni que cada año se esfuerzan por conseguirlo.

Elena Eguizabal Martínez. Medicina.
Convocatoria: MIR.
Puesto 37º de 14.062.
Plazas ofertadas: 7.989 plazas.
“Comencé a estudiar en enero del año pasado, -explica Elena- pero lo hice ya de manera más intensa a partir de junio”.
Esta futura “residente” de Medicina recuerda que “le dedicaba unas 8 horas diarias al estudio y, para organizarme mejor, me apunté a una academia especializada en la preparación de exámenes MIR que hay en Bilbao”.
A pesar del esfuerzo, también había tiempo para el ocio: “Me reservaba un día a la semana para quedar con la cuadrilla, incluso -añade- me tomé alguna semana de vacaciones, para desconectar”.
«Hubo mejores y peores momentos, pero nunca se me pasó por la cabeza tirar la toalla»
“Los últimos días fueron muy intensos. El anterior al examen me lo tomé libre y mantuve la cabeza ocupada en otras cosas: quedé con las amigas, fui a la peluquería… todo aquello que me ayudara a estar distraída”, recuerda.
A Elena le gustaría hacer Medicina Interna en Euskadi o en Navarra; “lo estoy pensando... pero todavía hay tiempo hasta el momento de la elección”, afirma ya más relajada y sin la presión de hace unas semanas.

Laura Caballero. Enfermería.
Promoción de 2011
Convocatoria: EIR.
Puesto 21º de 7.225.
Plazas ofertadas: 1.683 plazas.
El caso de Laura es diferente. Finalizó el grado en 2011 y comenzó a trabajar como enfermera en diferentes servicios de la Atención Primaria de Osakidetza. Con los años, entendió que era el momento de dar el salto y profundizar en alguna especialización. De entre las opciones que se le presentaban optó por presentarse al EIR.
“Comencé a estudiar por mi cuenta en 2019 y me presenté a las pruebas de 2020”, recuerda. “Estudiaba y trabajaba, a la vez. No pude prepararlo bien, -explica- y el resultado no fue bueno, pero me valió para tener una idea de a qué me enfrentaba”.
«Pude dejar el trabajo gracias a los ahorros y preparé a tiempo completo los exámenes»
“Al año siguiente -continúa- pude dejar el trabajo gracias a los ahorros que había conseguido, me inscribí en una academia y preparé a tiempo completo los exámenes”.
Dedicaba al estudio de ocho a diez horas, de lunes a sábado. Aún así, Laura asegura que no cree “que haya sido el peor año para prepararlo”.
“La situación provocada por la pandemia nos ha obligado a permanecer mucho tiempo en casa, en lugar de estar disfrutando con las amistades -añade-; así que se ha hecho menos duro el concentrarse y dedicarle el tiempo necesario”.
En todo el tiempo de estudio no hubo ocasión para el desánimo; sin embargo, asegura que cuando comenzó lo más duro de la crisis sanitaria, sintió que “debía echar una mano y cuando pidieron personal para colaborar en los centros de Osakidetza, me puse en contacto con el Colegio de Enfermería para ponerme a su disposición si hiciera falta”.
El apoyo familiar y de las amistades y el estar preparando el examen con una amiga que optaba a una plaza MIR, le motivó más todavía.
Luego, en los días previos al examen “comienzas a darle vueltas a todo, tienes muchos nervios y empiezas a pensar si has hecho lo razonable: dejar un trabajo estable y que te gustaba por hacer este examen que no sabes cómo va a acabar”, recuerda.
Ahora, tras ver los resultados y con opciones a casi cualquier plaza cerca de casa, cree que optará “por una plaza Enfermería Familiar y Comunitaria; pero también me encanta la Pediatría, la Salud Mental…”.

Malen Ezeiza Zapiain. Enfermería.
Convocatoria: EIR.
Puesto 24º de 7.225.
Plazas ofertadas: 1.683 plazas.
Malen comenzó a preparar el examen exactamente un año antes. Durante ese tiempo tuvo tiempo para estudiar y desconectar, asegura: “La Academia nos enviaba la planificación de los temas a estudiar cada día y, en general, la seguía sin problemas. Por las mañanas iba a la biblioteca y estudiaba. Después de comer pasaba estudiando un par de horas más. Luego me lo tomaba libre para desconectar de los estudios y hacer algo que me gustara”.
«Cuando había más dificultad o cansancio, aparcaba los estudios y me decía: mañana se aclarará»
¿Desánimo? “Yo no utilizaría esa palabra -asegura- pero es un proceso largo y tienes tus altibajos, como todo el mundo. En los peores momentos intentaba ser lo más prudente posible: cuando había más dificultad o mayor cansancio, aparcaba los estudios y me decía: mañana se aclarará”.
“En la academia nos recomendaron no estudiar el día antes del examen. Les hice caso y traté de tener la cabeza alejada de todo lo relacionado con el examen: con amigas, en el monte…”, recuerda Malen.
Y en la hora crucial, en la del examen, la futura EIR trató de recordar lo que se había dicho durante todo el año de estudio: “Debo estar tranquila. Así que intenté mantener la idea de que sabía muchas cosas, en lugar de centrarme en lo que no sabía”. “A la hora de preparar un examen de este tipo, siempre se puede aprender más, pero quienes nos presentamos estamos en una situación parecida: cosas que sabemos mejor y otras peor”, concluye.
En julio, tras el reparto de plazas, comenzarán la “residencia”. A Malen le gustaría comenzar estudios de matrona; hasta entonces, continuará trabajando como enfermera en la campaña de vacunación.

Imanol Naharro. Farmacia.
Convocatoria: FIR.
Puesto: 13º de 1.582.
Plazas ofertadas: 267 plazas.
“Comencé a preparar el FIR a tiempo completo en verano, cuando recibí el material de la academia”, explica Imanol.
“Todos los días definía los objetivos a cumplir, pero siempre trataba de evitar dedicar más de ocho o nueve horas diarias al estudio. Entendí que invertir más horas en ello era contraproducente y, por ello, procuraba guardar un rato del día para salir a la calle o hacer otras cosas”, recuerda.
“¿Si me desanimé en algún momento? ¡Pues, claro!”, asegura. “Eso forma parte de este tipo de exámenes a largo plazo: resulta complicado mantener la disciplina y no tener momentos de distracción e, incluso, abatimiento, cuando uno tiene que ponerse a diario a estudiar algo de lo que no verá sus frutos hasta pasados varios meses. Por suerte, contaba con mi pareja, que también estaba preparando esta oposición, y mi familia para recuperar los ánimos y continuar luchando por una plaza”, afirma.
«Todos los días definía los objetivos a cumplir, pero evitaba dedicar más de ocho o nueve horas diarias al estudio»
El día anterior al examen no tocó un apunte: “Sabía que solo serviría para ponerme más nervioso”. Con el fin de quitarse presión, Imanol optó por decirse a sí mismo “que si no salía bien tendría más oportunidades en el futuro”. Y funcionó… junto con el resto de la estrategia, claro”.
Y ahora, ¿qué? “No tengo demasiado claro que especialidad escoger -duda-; de primeras diría que Farmacia Hospitalaria es la que más me atrae, pero no descarto Microbiología. Lo que sí tengo bastante decidido es que optaré por una plaza en Euskadi para seguir cerca de los míos.

Saioa Rojas. Psicología.
Convocatoria: PIR.
Puesto: 69º de 4.333.
Plazas ofertadas: 198.
“La primera vez que lo intenté fue en 2018, tras hacer un máster en ‘Psicooncología y Cuidados Paliativos’, recuerda. “Me lo tomé como una aproximación al temario y para establecer rutinas de estudio. En esta ocasión -continúa- me he apuntado en una academia para organizarme mejor y amplié mi horario de estudio a 10-12 horas diarias”.
“Este año ha sido todo más caótico -lamenta Saioa-. A la incertidumbre y preocupación por la situación sociosanitaria, había que añadirle la restricción de las clases presenciales y limitar el contacto con los compañeros, con lo que ello aporta”.
No era la primera vez, así que Saioa trató de mejorar sus puntos débiles: “Mejorar las técnicas del examen, consolidar las materias en las que flojeaba y completar el material que tenía con otras informaciones que recopilaba de otras fuentes”.
«Este tipo de exámenes dependen mucho del conocimiento, pero también de una adecuada gestión emocional»
En todo este tiempo Saioa se planteó “abandonar la aventura en muchos momentos, porque es un proceso largo y duro, que supone muchos altibajos emocionales, renuncias personales y sacrificios”. “¿Cómo lo he superado?: gracias a una fantástica familia y amistades que me han apoyado y, también, porque he cuidado mi salud física y emocional”, explica.
Enfrentarse al examen tampoco fue fácil. “Los nervios son mi mayor enemigo -reflexiona- tenía las experiencias anteriores, en la previa estuve muy nerviosa, llegué sobrecargada y con mucha ansiedad; eso me impidió concentrarme en el examen y cometí errores. Este año -continúa- he llegado con mayor seguridad en mí misma. Reconozco que, al leer el examen pensé que no tenía posibilidades, pero decidí luchar cada pregunta y no rendirme”. Está segura de que “este tipo de exámenes dependen mucho del conocimiento, pero también de tener una adecuada gestión emocional”.
¿Y ahora? “Pues… después de la locura y las emociones de la noticia, quiero descansar y disfrutar del momento, informarme de las plazas que me puedan interesar y, hasta que empecemos, leer algún libro que tenía pendiente”.

Martín Barainka. Bioquímica y Biología Molecular.
Convocatoria: BIR.
Puesto: 29º de 1.113.
Plazas ofertadas: 50 plazas.
Martín finalizó los estudios en 2019 y decidió tomarse un año sabático en Australia con un permiso ‘Work & Holidays’, “para estudiar inglés y plantearme qué quería hacer en el futuro”, explica. Ocho meses después comenzó la pandemia y volvió con la idea de presentarse a las pruebas del BIR.
Martín también se inscribió en una academia. “Al principio comencé a estudiar suave -recuerda-, alrededor de ocho horas, que luego pasaron a ser diez, entre estudios y test”.
Viendo la botella medio llena, asegura que “la pandemia y las restricciones me ayudaron, porque no podía salir mucho. Al principio los sábados, y luego… ni eso”. Poco descanso hubo durante todo este tiempo de estudio: “Me tome algún día, cuando estaba ya agotado, además de los días de Navidad y Año Nuevo, pero nada más”.
«La pandemia y las restricciones me ayudaron, porque no podía salir mucho. Al principio los sábados, y luego… ni eso»
Hubo momentos de desánimo, recuerda: “Al principio, con algunas materias que no había dado en mi especialidad; luego, poco a poco, fui controlándolo y me tranquilicé. Además, -añade- me lo planteé como una prueba, lo que me quitaba presión y me ayudaba a seguir estudiando sin tener tanta carga”.
El día definitivo no fue para tanto, asegura Martín. “En selectividad ya pasé por algo parecido y no suelo ponerme muy nervioso. Además, tenía ganas de hacer el examen, de recuperar la rutina y volver a la calle con los amigos. El último día lo dediqué a repasar alguno de los temas que no solían caer, por si acaso”, recuerda.
En cuanto a la elección de plaza, explica que le atrae la Inmunología. “De todas maneras -continúa-, aquí no hay plazas de ninguna de las cuatro especialidades a las que puedo optar y lo más cerca es Navarra o Santander; además de Madrid o Barcelona. Así que ya veremos…”.

Adrián Hierro. Física.
Convocatoria: RFIR
Puesto: 14º de 217
Plazas ofertadas: 40 plazas.
“Comencé a estudiar justo después de entregar el TFG, en julio del año pasado”, recuerda Adrián.
“Los primeros meses estudiaba por las mañanas, dos o tres horas, cinco días a la semana y, a partir de enero, me di cuenta de que el examen estaba cerca y subí a cinco horas diarias” explica este joven físico.
Hubo momentos en los que comenzó a dudar si le “daría tiempo para estudiar y repasar toda la materia y eso hacía más difícil ponerse con ganas el estudio diario”, reconoce.
«No noté los nervios hasta que estaba en la cola para entrar al examen»
Y, así, llegó el día previo al examen: “Me acosté tarde e intenté dormir todo lo que pude para que la espera hasta empezar la prueba fuera lo más corta posible -recuerda-. Aunque, la verdad, no noté los nervios hasta que estaba en la cola para entrar al examen”.
A Adrián le gustaría “encontrar trabajo cerca de donde he vivido siempre, en Barakaldo”; así que buscará plaza en algún centro cercano. Y, por el puesto en que ha quedado, no parece que vaya a tener muchos problemas por lograrlo.
En unos pocos meses Elena, Laura, Malen, Imanol, Saioa, Martin y Adrián habrán elegido especialidad y lugar donde llevar a cabo el periodo de residencia. Mientras tanto, disfrutarán de un merecido descanso. ¡Zorionak a los siete y a todos los EHUalumni que han superado la prueba!